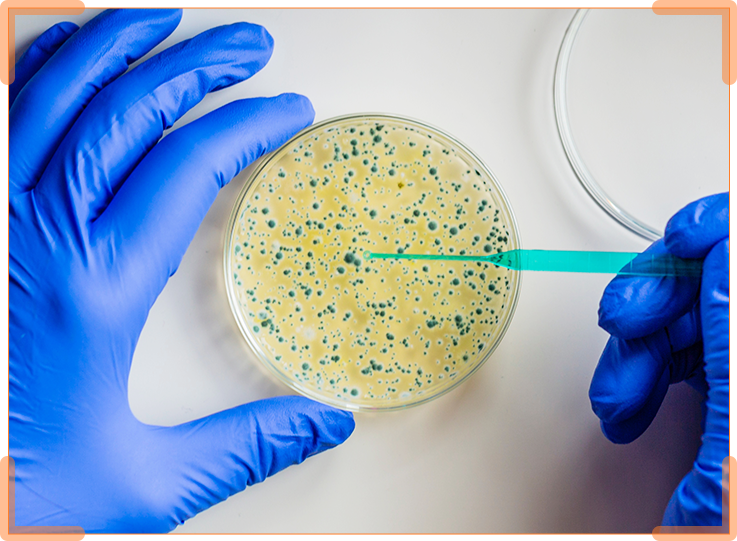

1. Product Description
USB Object Camera (Document Camera)
Introducing the U50+ Object Camera — a special device that helps teach effectively. With impressively smooth images at 60 frames per second and an 8-megapixel lens, the U50+ captures every detail in vivid resolution. Additionally, the flexible handle ensures easy portability and convenient storage. Free AVerTouch software enhances lessons by enabling high-quality photography, real-time recording, and uploading content to the cloud through Google Classroom for an interactive and reflective learning experience . Professional, convenient and interactive classroom content with U50+ whether you are in class or remotely.
High-end object cameras deliver professional image quality
Equipped with a high-resolution camera of up to 8 megapixels and a 16X digital zoom lens, the U50+ allows teachers to present realistic text/picture books or objects with exceptional clarity. This ability helps learners grasp every learning detail, enhancing their study sessions through excellent understanding.
With just one USB to set up
The U50+ only requires a single USB cable for both power and connectivity. This simple setup allows teachers to start lessons anytime and from anywhere, making the U50+ an invaluable tool for distance learning and hybrid classrooms.
Mobile design
The U50+ is designed for easy portability. An integrated handle makes portability easy, while the tight-fitting camera head frame and flexible arm design ensure that the U50+ remains secure when you carry it with your teaching kit.

One Camera for Many Angles & Functions
U50+ is both a display camera device (Document Camera) and a webcam. Its flexible arm can bend at any angle, allowing teachers to present teaching material their way. But even without material to present, teachers can still use the U50+ as a webcam, eliminating the need to use additional devices to start remote classes.
3-level LED light suitable for more situations
Equipped with integrated 3-level LED lighting, the U50+ gives teachers greater flexibility to adapt to different lighting conditions in the learning environment. Easily adjust the light level by pressing the LED button located on the top edge of the camera. This feature is especially useful in dark environments, serving as a useful tool for teachers.
Free AVerTouch software enhances remote teaching capabilities
Simply connect your U70i with one touch to start sharing content and annotations instantly as you go. With easy and intuitive functions—as well as cloud synchronization for automatic backup of your annotations, photos, and recordings—this software enriches the teaching experience with interactivity unprecedented. You can even take photos and record videos via Google Classroom by connecting the U70i with AVerTouch software.
2. Specifications
Camera
-
- Image sensor: 1/3.2” CMOS
- Output resolution: Up to 8M (3264 x 2448)
- Total Pixels : Megapixels
- Zoom: 16X digital zoom (via software)
- Frame rate: 60 fps (maximum)
- Focus: Auto focus, manual via software
- Image capture area: Larger than A3 size (420 x 315 mm)
- Image rotation: Rotate 0° / 180° (by button); Electronic rotation 0° / 90° / 180° / 270° (via software)
- Image effects: Color / B&W / Freeze (via software) / Negative (via software)
- Image correction: Yes, via software
- Presentation tool: Spotlight / Visor (via software)
- Flicker filter control: Yes (50 / 60 Hz)
- Recording: Yes, via software
- Capture :Single / Continuous (via software)
- Note: Yes, via software
- AI Noise Reduction: Yes
- AI Image rotation: Yes (0° / 180°)
- Light source: Integrated LED light
- Mic: Built-in
- Mini USB 2.0 port: 1 Out
** Specifications may vary by country and are subject to change without notice.